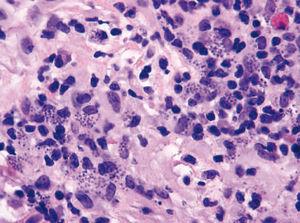

Sr. Director:
Las leishmaniasis son parasitosis originadas por protozoos intracelulares del género Leishmania. Estos microorganismos son transmitidos a través de la picadura de la hembra del díptero perteneciente al género Phlebotomus en el Viejo Mundo y Lutzomya en el Nuevo Mundo. Las manifestaciones clínicas de las leishmaniasis son muy variadas, describiéndose formas cutáneas, mucocutáneas y viscerales de la enfermedad1,2. Presentamos un caso de leishmaniasis cutánea con diseminación esporotricoide, una variante muy poco frecuente de esta entidad y excepcional en nuestra área geográfica.
Se trata de una mujer de 63 años de origen ecuatoriano, sin antecedentes personales de interés. Tres semanas después de su llegada a España consultó por presentar en la región facial una lesión de 2 meses de evolución, de crecimiento progresivo y ocasionalmente pruriginosa. No refería ninguna otra sintomatología asociada. Tampoco recordaba picaduras de insecto ni traumatismos previos a su aparición.
La exploración física mostró una placa infiltrada de unos 3× 3 cm de diámetro localizada sobre la rama mandibular izquierda. La superficie era eritematosa, lisa, brillante y presentaba una pequeña ulceración cubierta por una costra. Además, en la periferia de la lesión se palpaban cordones indurados y pequeños nódulos subcutáneos siguiendo el trayecto de los linfáticos proximales (fig. 1).
Figura 1. Placa eritematosa ulcerada. Cordones y nódulos subcutáneos extendiéndose en sentido proximal.
Se realizó hemograma, bioquímica hemática, proteinograma, radiografía de tórax y aspirado de médula ósea con resultados normales. Los cultivos del exudado para bacterias, hongos y micobacterias fueron negativos.
La tinción con Giemsa del frotis del exudado permitió la visualización directa de amastigotes dentro y fuera de los histiocitos.
En el estudio histopatológico, además de un denso infiltrado inflamatorio constituido por linfocitos, células plasmáticas y algunos eosinófilos, se apreciaron macrófagos parasitados por microorganismos basófilos ovales de uretoplasto excéntrico y carentes de cápsula (fig. 2).
Figura 2. Múltiples macrófagos parasitados por amastigotes. (Hematoxilina-eosina, ×40.)
Con los hallazgos clínico-citológicos observados se estableció el diagnóstico de leishmaniasis cutánea esporotricoide. La paciente recibió antimoniato de meglumina (Glucantime®) a dosis de 20 mg/kg/día de antimonio pentavalente por vía intramuscular durante 28 días, con buena tolerancia y resolución completa del cuadro.
La leishmaniasis cutánea habitualmente se manifiesta como pápulas o placas de color rojo vinoso, generalmente únicas, infiltradas, que con frecuencia aparecen ulceradas y cubiertas por una costra serohemática. Estas lesiones se conocen también con el nombre de «botón de oriente»1-3. En algunas ocasiones se han descrito variantes clínicas muy poco frecuentes, como la forma esporotricoide4-10, caracterizada por la existencia de nódulos y cordones subcutáneos debidos a la diseminación linfática locorregional de la enfermedad. Estos nódulos representan una reacción inmunológica frente a la expansión linfática directa del parásito o sus antígenos6. Asimismo, también se han descrito otras formas atípicas de leishmaniasis cutáneas como eczematiformes, hiperqueratósicas, verrugosas y papilomatosas, zosteriformes, erisipeloides, lupoides, fagedénicas, tumorales o manifestaciones clínicas en forma de macroqueilia o paroniquia1,4.
Esta particular forma de presentación de la leishmaniasis cutánea esporotricoide plantea diagnóstico diferencial con numerosas entidades que incluyen: tuberculosis cutánea, lepra tuberculoide, infección por micobacterias atípicas, esporotricosis, nocardiosis, actinomicosis, micetomas, piodermitis chancriformes y tumores, sobre todo epiteliomas espinocelulares y linfomas1-3.
La diseminación esporotricoide conlleva además implicaciones terapéuticas, pues en estos casos se debe instaurar tratamiento sistémico. Como primera elección se utilizan los antimoniales pentavalentes como el antimoniato de meglumina (Glucantime®) o el estibogluconato de sodio (Pentostam®) por vía intramuscular o intravenosa. Como alternativas se han empleado anfotericina B liposomal, itraconazol, ketoconazol y pentamidina1-3,11.
En resumen, consideramos que, aunque la leishmaniasis cutánea esporotricoide no es habitual en nuestro medio, debemos tenerla presente para realizar un diagnóstico precoz y una rápida instauración del tratamiento específico.
Agradecimientos
Agradecemos la colaboración prestada por la Dra. Teresa Gárate y su equipo del Servicio de Parasitología del Centro Nacional de Microbiología del Instituto de Salud Carlos III de Madrid.